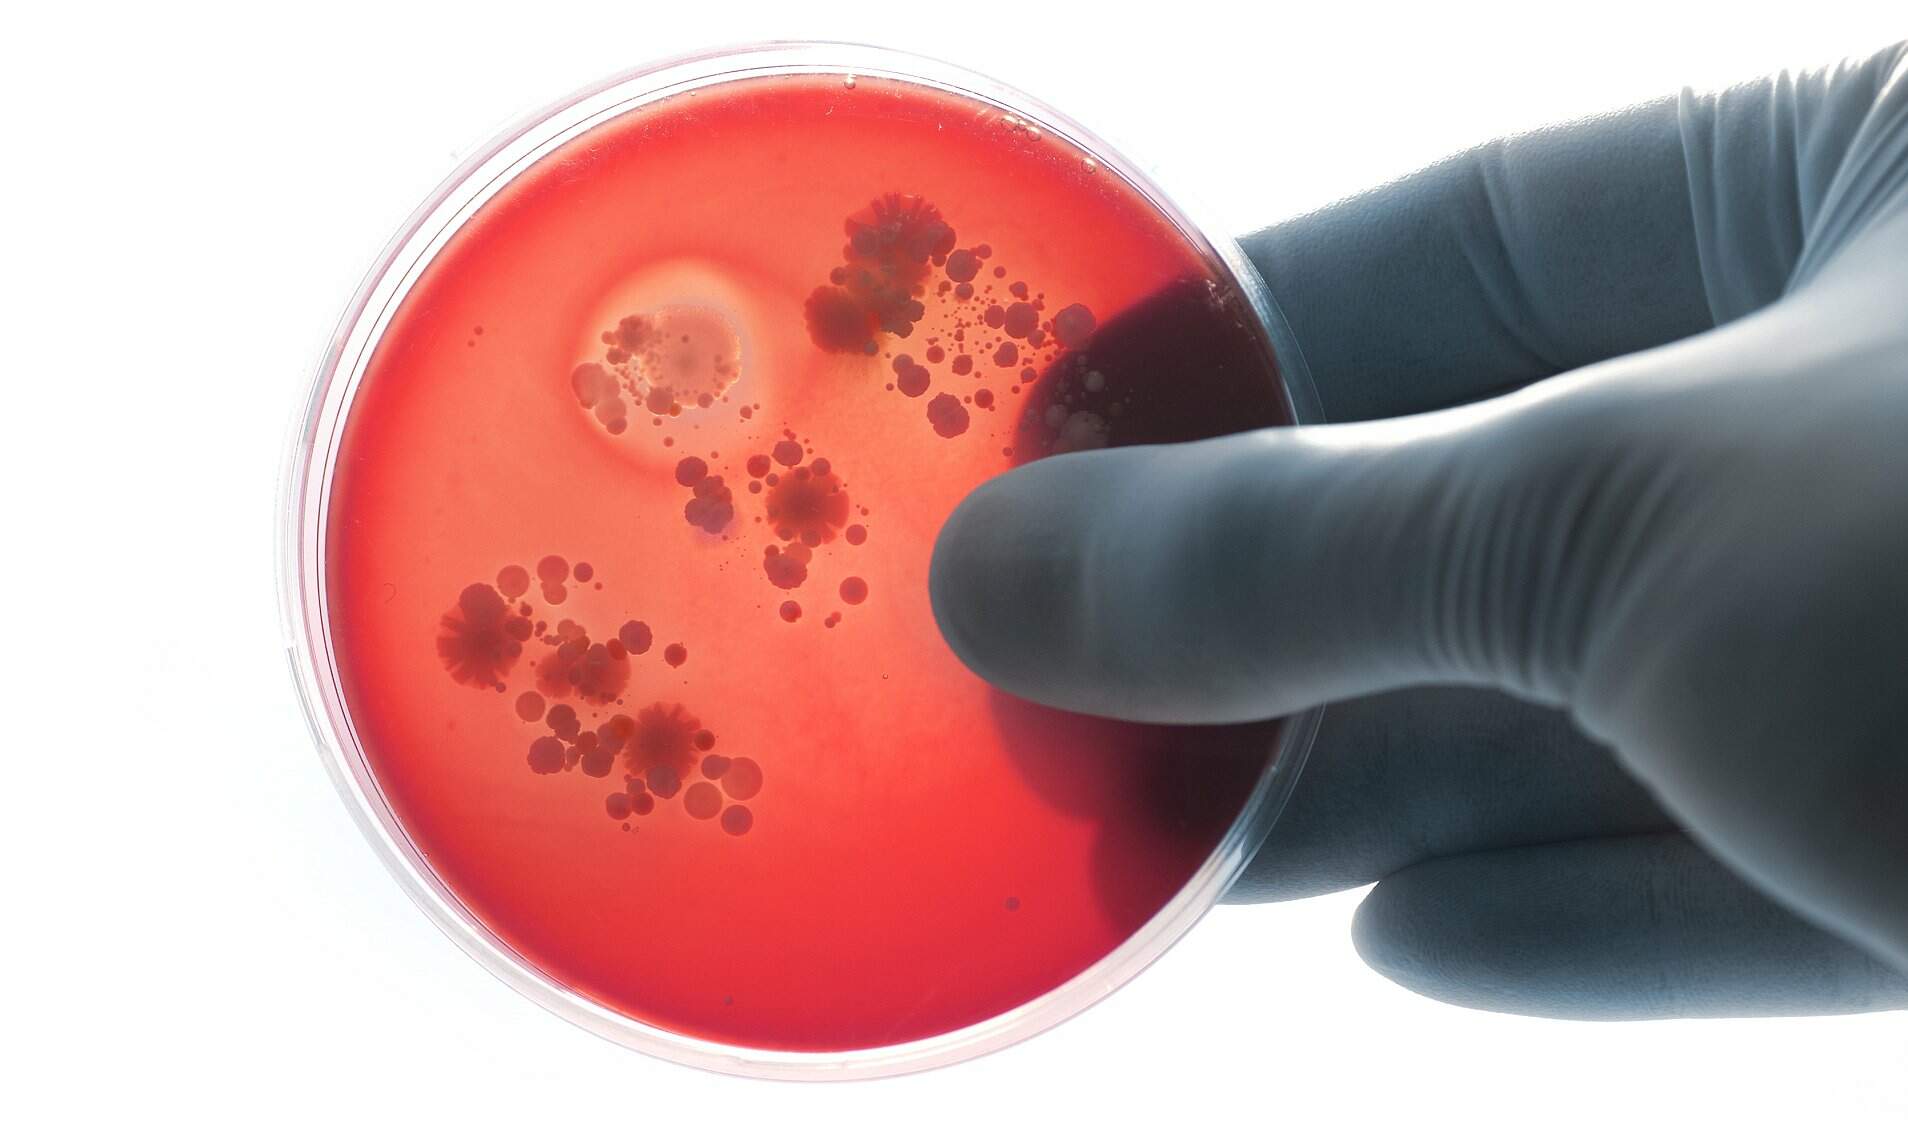

Brasil O ministro do Turismo negou ameaça de morte e ironizou a aparência de acusadora
Por Redação O Sul | 20 de novembro de 2019

Na segunda audiência que compareceu no Congresso para responder às acusações de ter montado um esquema de candidaturas laranjas no PSL de Minas Gerais, o ministro do Turismo, Marcelo Álvaro Antônio, foi questionado publicamente nesta quarta-feira (20) sobre a suposta ameaça de morte que teria feito contra a deputada federal Alê Silva (PSL-MG).
Sentada na primeira fileira da Comissão de Defesa dos Direitos da Mulher, a própria deputada se dirigiu diretamente a Álvaro Antônio e reiterou a acusação de que ele, por meio de interlocutores, a ameaçou de morte caso ela o incriminasse no caso das laranjas.
“‘Falem com a Alê parar com isso senão eu acabo com a vida dela’, o senhor falou isso, o senhor falou isso, ou então tem muita gente mentindo”, disse a deputada “A senhora mente”, respondeu o ministro.
Ao negar a existência de ameaça de morte, Álvaro Antônio ressaltou que não tem perfil violento e ironizou a aparência física da deputada, afirmando que jamais ameaçaria alguém, “ainda mais uma pessoa que, para mim, já deve estar chegando na terceira idade, pelo menos no aspecto, uma pessoa mais velha” — Alê Silva tem 45 anos e é cinco meses mais jovem que o ministro, que também tem 45 anos.
“A deputada se aliou à Folha e ao PSOL ultimamente, com um trabalho muito afinado com o PSOL e os partidos de esquerda, nunca ameacei ninguém de morte”, disse o ministro.
Criticado por deputadas da comissão sobre por que falou sobre a idade da parlamentar, afirmou apenas que quis se referir a uma “senhora” e que em nenhum momento agiu de forma pejorativa.
A deputada, que também é aliada do presidente Jair Bolsonaro (sem partido), afirmou que jamais encontrou indícios de que o presidente tenha participado do esquema e afirmou que ele só mantém Álvaro Antônio no cargo por gratidão pessoal, porque o ministro estava em Juiz de Fora (MG) no dia em que o então presidenciável sofreu tentativa de assassinato, em 6 de setembro de 2018, auxiliando no seu socorro.
A Folha de S.Paulo revelou, em reportagens publicadas desde fevereiro, que o PSL montou um esquema de candidaturas laranjas em Minas Gerais, comandado à época por Álvaro Antônio, e em Pernambuco, terra do presidente da legenda pela qual Jair Bolsonaro se elegeu, Luciano Bivar.
O ministro do Turismo foi indiciado pela Polícia Federal e denunciado pelo Ministério Público por três crimes.
Em abril, Alê Silva acusou em depoimento à Polícia Federal ter recebido relato de ameaça de morte vinda do ministro, que estaria vislumbrando nela a origem das denúncias que pesam contra ele.
No depoimento aos deputados, Álvaro Antônio voltou a negar a existência de esquema de laranjas e criticou por diversas vezes a Folha, afirmando, em síntese, que o jornal fez um julgamento antecipado de sua conduta, sem elementos para tanto.
Apesar de apontar e citar nominalmente por várias vezes o repórter do jornal presente à audiência, ele não quis responder às perguntas dos jornalistas, ao final da sessão, deixando o local às pressas. A Folha também já ofereceu por diversas vezes espaço para uma entrevista com o ministro ou seus defensores, mas nunca houve resposta.
Conforme mostraram as reportagens, posteriormente corroboradas pelas investigações da PF e do Ministério Público, quatro candidatas do PSL escolhidas por Álvaro Antônio receberam altas quantias de verba pública do partido e tiveram votação ínfima, sinal clássico de campanhas de fachada. Parte desse dinheiro foi parar na conta de empresas ligadas a assessores e ex-assessores do ministro.
Questionado sobre isso na comissão por deputadas do PSOL, ele não respondeu.
“Houve uma investigação longa e extensa da PF, mais de 80 pessoas ouvidas, buscas e apreensões na sede do partido. Telefone celulares, HDs [apreendidos], não existe um só elemento, um só depoimento que me atribua qualquer procedimento inadequado”, discursou Álvaro Antônio.